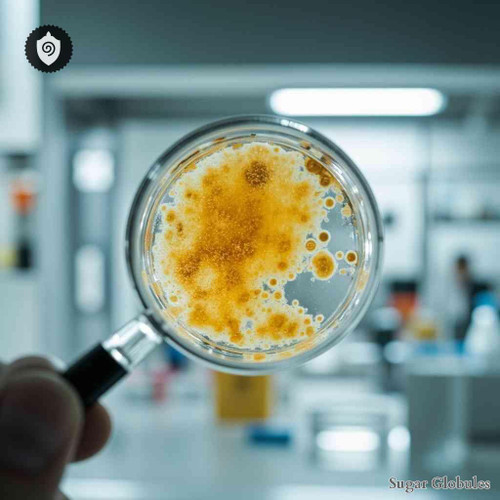
Escherichia Coli Bovinum Nosoda sugar orbs in pellet form for energetic homeopathic (nonmedical) physical product presentation

Sugar Globules
Sugar Globules are small sugar spheres used as a physical carrier for the vibrational or informational imprint of your selected element. Through the process of Remote Encoding (but infused with a distinct energetic meta-frequency, delivering a stronger charge) and the unique principles of Informational Homeopathy (nonmedical), each granule is encoded with an energetic intention or frequency pattern. Once encoded, the globules are carefully packaged and shipped worldwide. This format is ideal for meditation, energy field alignment, and personal vibrational practices focused on wellness and balance.
For all products or services in this category, the relevant element or energetic reference is shown before the colon (:) in the product name. Please use that part of the title when making your selection. All descriptions and pictures of products are intended solely to improve website SEO.
Names listed before the colon precisely define the frequency (imprint) being offered.